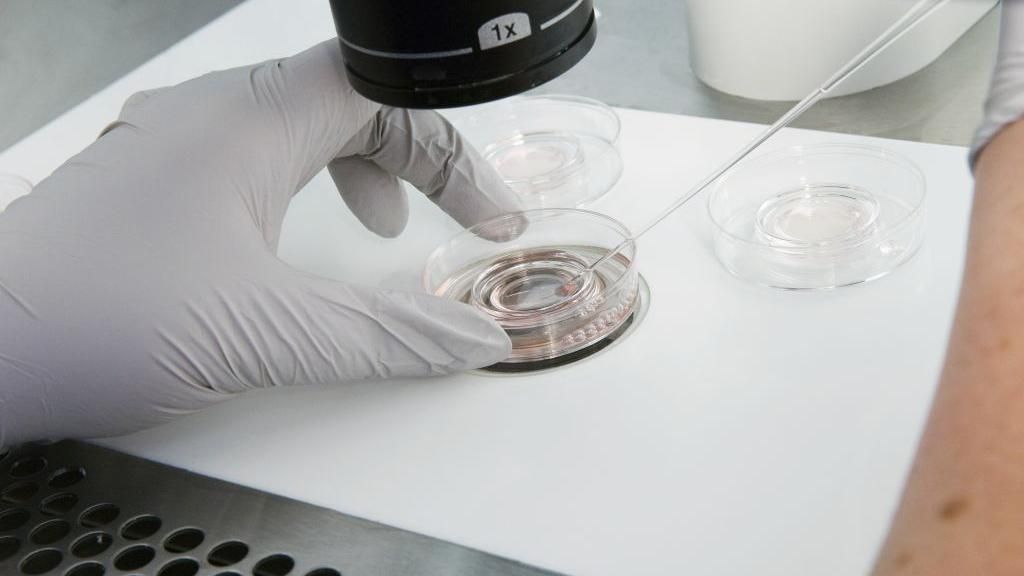
A gloved hand holds a petri dish under a microscope

I lost £15,000 after going to an IVF middleman

IVF patients are being warned over unregulated "concierge clinics" after a popular one went bust leaving scores of clients without treatment or refunds.
As the number of privately funded IVF cycles has risen, online concierge companies have emerged, acting as "middlemen" between patients, donors and doctors.
The fertility watchdog has said that as these clinics do not provide IVF treatment directly, it does not have powers to regulate them. It is calling for the law to be strengthened to protect patients.
Syreeta Sandhu lost nearly £15,000 when her concierge clinic went bust. "You're on your knees," she said. "Upset has turned to frustration and anger."
The 40-year-old mother-of-two contacted online firm Apricity Fertility after four failed rounds of IVF and five miscarriages, in the hope of having a third child.
She paid Apricity, which matched her with an egg donor and contracted established clinic King's Fertility. She was due to start treatment in December last year when her appointments were cancelled without explanation.
Syreeta found out via the company's app that it was ceasing operations on 1 January.
When she contacted King's, the clinic said data protection rules meant it did not have access to her file or details of her egg donor. It had not been paid by Apricity so her treatment could not begin.
"When you're on this journey, every month counts. You'll do anything, and you do throw lots of money at it," she said.
"It takes a long time to meet [medical staff] you can trust," she said. "I spent almost 12 months building that trust and it just dropped off."

Concierge clinics offer services like matching patients with donors and doctors, booking appointments and posting medication.
It is not clear how many there are operating in the UK but experts believe their number is growing.
Satellite arrangements – where patients attend medical appointments with one doctor, usually their own GP, and then undergo the IVF process elsewhere – is an established set-up in fertility care. But concierge clinics don't have physical premises or store eggs, sperm or embryos themselves.
The fertility watchdog, the Human Fertilisation and Embryology Authority (HFEA), is warning patients that these new services are not covered by its protections.
Clare Ettinghausen, director of strategy and corporate affairs at the HFEA, said: "The fallout from Apricity's closure and the effect it had on patients highlights how the current law does not reflect the range and type of fertility treatments being offered today."
She said the watchdog was calling for the Human Fertilisation and Embryology Act to be revised to take account of the different ways fertility services are provided.
Syreeta is one of 52 patients owed money by Apricity. The company owes a total of £119,000 to its patients, according to the liquidator appointed to manage its debts, Cork Gully.
'There was no communication'

Beth Rodgers, 32, from Belfast has Turner syndrome, a rare genetic condition that means her ovaries do not produce eggs. Because Northern Ireland has a severe shortage of donor eggs, Beth had to secure a donor in England.
She and her partner paid Apricity £4,600 and had been matched with an egg donor.
"Then I saw a comment on a Facebook group saying 'thinking of everyone affected by the Apricity news,'" she said. "There was no communication, no number to call."
The couple were able to claim some of the money back on their insurance but it did not cover a £385 fee for a doctor's appointment and £985 for donor compensation.
"Time was probably the biggest thing I felt I lost. It was such a long process," said Beth.
She has now restarted treatment with a regulated clinic. She has had appointments with a doctor in the Republic of Ireland and travelled to Manchester for the embryo transfer.
That transfer was unsuccessful but she will be able to get another round of IVF on her insurance with a different egg donor.
'No realistic chance of a refund'
In recent years, more British couples have paid for private fertility treatment, in part because IVF on the NHS is a postcode lottery.
Jonathan, not his real name, and his wife went through five failed rounds of IVF before they went to Apricity. They paid £10,000 for treatment with their savings and a loan.
"We've been told there's no realistic chance of getting our money back," he said. "We haven't been able to resume treatment yet as we're still trying to raise finance."
Cork Gully told Jonathan and other patients in a letter seen by the BBC: "It is unlikely that there will be funds to pay to patients."
It said any affected patients should get in touch.
The BBC asked Mel Chacksfield, who was chief executive of Apricity when it ceased operations, why the business had gone under and if patients would be refunded but she did not respond to our request.
However, Caroline Noublanche, one of the company's founders and the previous chief executive, told the BBC it had "faced sudden and irreversible financial difficulties in December when planned investment from an investor was withdrawn".
Clinics falling into regulatory gap
Prof Emily Jackson is a researcher in medical law and ethics at the London School of Economics. She said: "You need a licence to do things with embryos and sperm and eggs but you don't need any licence to offer to arrange things on the internet.
"For people thinking about their options, it is probably sensible to opt for treatment in an HFEA-licensed clinic, because they have responsibilities towards patients in the event of closure."
Those responsibilities mean that if an HFEA-licensed clinic closes, it has to give patients information and ensure they are supported.
The clinic must also ensure all eggs, sperm and embryos that are in storage are kept safe.
A spokesperson for the Department of Health and Social Care told BBC News: "While digital or 'virtual' clinics do not currently fall within the remit of the Human Fertilisation and Embryology Authority, ministers have met with its chair to discuss the emerging regulatory challenges.
"The government is currently considering the HFEA's recommendations on modernising fertility law. We would advise all those looking at using digital clinics to carry out thorough research before making any decisions."
King's Fertility, which was providing Syreeta's treatment, was a contractor of Apricity's and is now a creditor of the company.
Its director, Dr Ippokratis Sarris, a consultant in reproductive medicine, said it was likely more concierge clinics would emerge in the future as patients look for convenience and flexibility.
"The shift toward more remote and digital models of care is an inevitable progression in today's world. This is increasingly what patients want, and often prefer, so it's important that we don't deny them that choice."
But he advised patients to do careful research before choosing a provider, and to be cautious about paying upfront for multi-cycle packages.
"It's wise to look into how long a clinic has been established, who owns it (NHS, private individual, or private equity), and make an informed choice," he added.
"We shouldn't resist change, but we do need to be proactive in shaping it responsibly."

Get our flagship newsletter with all the headlines you need to start the day. Sign up here.
(Feed generated with FetchRSS)
